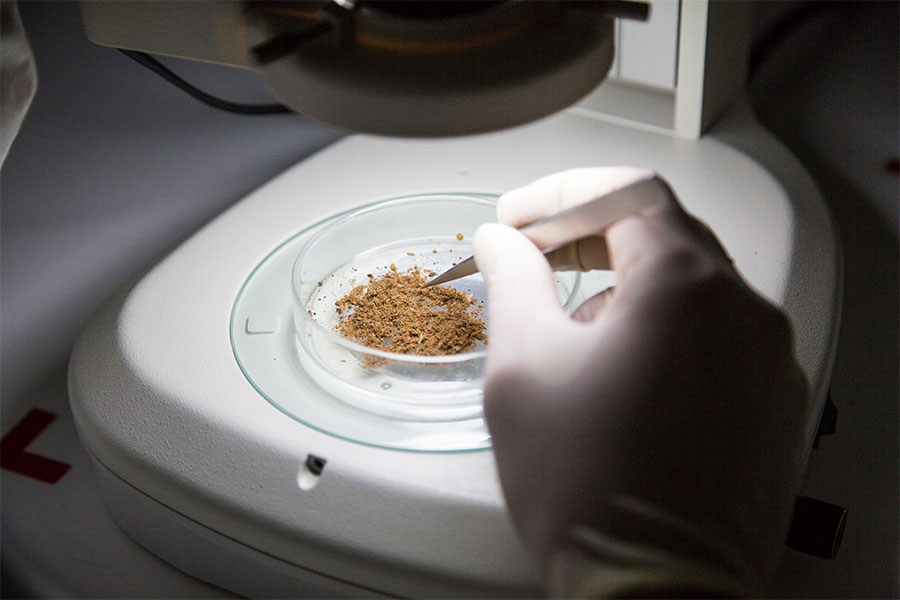

PerfectCompanionGroup好侶集團(tuán)為泰國正大集團(tuán)旗下企業(yè),1976年開始進(jìn)入寵物食品行業(yè),至今已有40多年的歷史,是亞洲寵物干糧最大的制造商。
目前,好侶集團(tuán)服務(wù)于全球20多個(gè)國家和地區(qū),年產(chǎn)能近400,000噸,品類包括犬糧、貓糧、魚糧、鳥糧、馬糧及嚙齒動(dòng)物糧等。
在泰國和中國,好侶集團(tuán)設(shè)有符合國際標(biāo)準(zhǔn)的現(xiàn)代化工廠,不僅擁有先進(jìn)的生產(chǎn)設(shè)備及制造工藝,還擁有自建的國家注冊(cè)實(shí)驗(yàn)室及卓越可靠的供應(yīng)鏈管理系統(tǒng)。此外,在寵物食品配方的研發(fā)領(lǐng)域,好侶集團(tuán)與泰國及美國的知名大學(xué)均已展開深入的合作與研究。
好侶集團(tuán)的中國工廠,好侶(中國)有限公司,成立于2012年,注冊(cè)資金7.5億元人民幣,工廠位于浙江平湖,占地面積75畝,年生產(chǎn)能力120,000噸,主要出口東南亞、歐盟、中東各地。旗下所有產(chǎn)品均符合美國飼料管理委員會(huì)(AAFCO)以及美國國家研究委員會(huì)(NRC)所制定的營養(yǎng)需求標(biāo)準(zhǔn)。目前工廠已通過ISO9001質(zhì)量管理體系和ISO22000食品安全管理體系認(rèn)證,并獲得BRC9食品安全全球標(biāo)準(zhǔn)A+級(jí)認(rèn)證。此外,公司擁有獨(dú)立的檢測中心,公司檢測中心已通過中國合格評(píng)定國家認(rèn)可委員會(huì)的認(rèn)可,獲得了CNAS實(shí)驗(yàn)室認(rèn)可證書,具備獨(dú)立的第三方實(shí)驗(yàn)室資質(zhì)。檢測中心目前開展的檢測項(xiàng)目涵蓋了寵物食品全部的營養(yǎng)指標(biāo)、毒素指標(biāo)和微生物指標(biāo),每一批產(chǎn)品均經(jīng)過嚴(yán)格的檢測,確保產(chǎn)品的質(zhì)量安全。
好侶集團(tuán)旗下?lián)碛蠸martHeart慧心犬糧、Me-O咪歐貓糧、IQDog聰明犬糧和IQCat聰明貓糧等自有寵糧品牌。在東南亞國家及中國均已上市,高質(zhì)量的產(chǎn)品獲得了各國消費(fèi)者的好評(píng)與青睞。SmartHeartPremier慧心臻選系列,添加了優(yōu)質(zhì)鮮肉,受到廣大寵物主人的極大喜愛。
SmartHeartPremier慧心臻選系列
以鮮肉為基礎(chǔ),輔以優(yōu)質(zhì)食材,增強(qiáng)腸道消化吸收能力,從而提升愛寵自身免疫力。
SmartHeart慧心系列
經(jīng)典配方,保護(hù)愛寵心臟健康,提高身體免疫,增強(qiáng)大腦功能,強(qiáng)健牙齒、骨骼和消化系統(tǒng),呵護(hù)皮膚健康,使毛發(fā)更加靚麗,具有泰國國民犬糧之美譽(yù)。
SmartHeartPowerPack慧心高能量配方
科學(xué)配方,為活力型及力量型犬種提供充分的能量,增強(qiáng)身體機(jī)能,保護(hù)心臟,強(qiáng)健骨骼增長肌肉,防止肌肉流失。
Me-O咪歐系列
精選原材料輔以科學(xué)調(diào)配,不僅美味可口,而且營養(yǎng)豐富。美味的海鮮,是貓咪的最愛。每一款都精選海鮮作為原材料,為“無肉不歡”的貓咪奉上一頓新鮮、健康的美食大餐。
IQCat聰明貓和IQDog聰明狗系列
全營養(yǎng)配方,多重礦物質(zhì),助力成長,超高性價(jià)比,適合多寵家庭。
除此之外,好侶集團(tuán)為歐尚大潤發(fā)、永輝和天虹等大型超市生產(chǎn)加工其自有品牌,將放心安全的寵糧送入千家萬戶。公司將始終秉承正大集團(tuán)“利于國家,利于人民,利于企業(yè)”的三利原則,不斷進(jìn)行追求和探索,為愛寵創(chuàng)造更美好健康的生活。
好侶集團(tuán)的中國工廠,好侶(中國)有限公司,成立于2012年,注冊(cè)資金7.5億元人民幣,工廠位于浙江平湖,占地面積75畝,年生產(chǎn)能力120,000噸,主要出口東南亞、歐盟、中東各地。旗下所有產(chǎn)品均符合美國飼料管理委員會(huì)(AAFCO)以及美國國家研究委員會(huì)(NRC)所制定的營養(yǎng)需求標(biāo)準(zhǔn)。目前工廠已通過ISO9001質(zhì)量管理體系和ISO22000食品安全管理體系認(rèn)證,并獲得BRC9食品安全全球標(biāo)準(zhǔn)A+級(jí)認(rèn)證。此外,公司擁有獨(dú)立的檢測中心,公司檢測中心已通過中國合格評(píng)定國家認(rèn)可委員會(huì)的認(rèn)可,獲得了CNAS實(shí)驗(yàn)室認(rèn)可證書,具備獨(dú)立的第三方實(shí)驗(yàn)室資質(zhì)。檢測中心目前開展的檢測項(xiàng)目涵蓋了寵物食品全部的營養(yǎng)指標(biāo)、毒素指標(biāo)和微生物指標(biāo),每一批產(chǎn)品均經(jīng)過嚴(yán)格的檢測,確保產(chǎn)品的質(zhì)量安全。
好侶集團(tuán)鄭重承諾:企業(yè)將客觀、科學(xué)、規(guī)范地遵守相關(guān)法律法規(guī)和質(zhì)量標(biāo)準(zhǔn)要求,建立健全質(zhì)量管理體系、完善質(zhì)量檔案,積極履行社會(huì)責(zé)任、重視質(zhì)量發(fā)展、大力開展質(zhì)量提升行動(dòng),切實(shí)做好關(guān)鍵過程質(zhì)量控制、質(zhì)量檢驗(yàn)和計(jì)量檢測、健全產(chǎn)品質(zhì)量追溯體系等工作,持續(xù)著力提升質(zhì)量水平,全力承擔(dān)保障質(zhì)量安全、履行質(zhì)量擔(dān)保責(zé)任及缺陷產(chǎn)品召回等法定義務(wù)的質(zhì)量主體責(zé)任,適時(shí)以相關(guān)方式對(duì)企業(yè)的產(chǎn)品和服務(wù)標(biāo)準(zhǔn)進(jìn)行必要的自我聲明,依法承擔(dān)質(zhì)量損害賠償責(zé)任,遵守市場秩序,維護(hù)公平競爭,切實(shí)維護(hù)消費(fèi)者合法權(quán)益。
主要產(chǎn)品:SmartHeart慧心犬糧、Me-O咪歐貓糧

京公網(wǎng)安備 11010502043458號(hào)